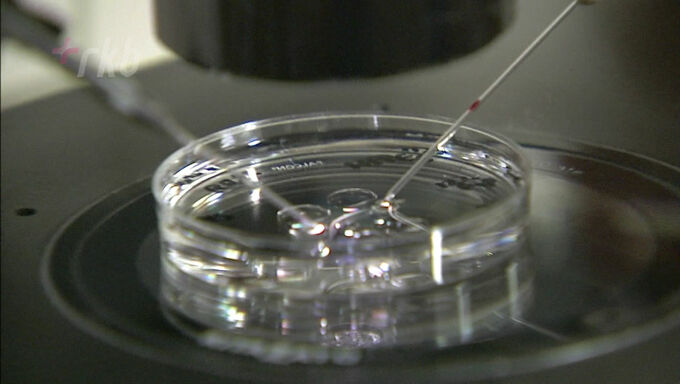

不妊症に悩む人の経済的な負担を軽くする取り組みです。福岡県は、保険が適用される治療に加え厚生労働省が認めた先進医療を受ける人に1回につき最大5万円の助成を始めます。
◆13の不妊治療が対象
新たな助成の対象となるのは保険が適用されないヒアルロン酸を用いた生理学的精子選択術や子宮内膜刺激術など厚生労働省が認めた13の不妊治療です。体外受精などの特定不妊治療は昨年度から保険が適用されるようになりましたが、先進医療を加える場合は経済的な負担が大きくなっていました。
◆1回につき最大5万円を助成

助成の対象者は福岡県在住で妻の年齢が43歳未満の夫婦で1回の治療につき最大5万円を助成します。申請の受付は6月1日からです。







